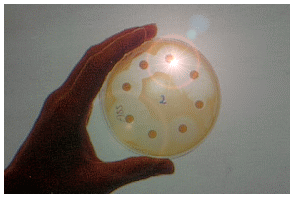

1.6 Abstriche aus der Mundhöhle, den Achseln und der Leiste
Um ganz sicher zu sein, das keine Infektionen mit Bakterien oder Pilzen vorliegt werden Abstriche aus den Bereichen Deines Körpers gemacht, die feucht, warm und meist ein wenig von der Luft abgeschlossen sind.
Diese Stellen sind bevorzugte Brutstätten von Pilzen und Bakterien. Bakterien und Hefen (Pilze) sind es übrigens auch, die den Körperschweiß zersetzen und ihn riechbar machen. Nachdem Du eine neue Lunge bekommen hast ist Dein Körper durch die Immunsuppression infektgefährdet.
Mehr noch: Pilze und Bakterien halten sich in der Natur die Waage. Die Bakterien halten die Pilze in Schach und die Pilze die Bakterien (z.B. durch das Pilzmittel Penicillin). Wenn nach Deiner Transplantation die Bakterien durch ein Antibiotikum weggeputzt werden, dann freuen sich die Pilze. Allerdings nur kurzfristig. Denn die werden dann ebenfalls durch ein Pilzmittel, ein so genanntes Fungizid in Schach gehalten.
1.6.1 Was ist ein Abstrich?
Wenn bei Dir der Verdacht auf eine Infektion mit Bakterien oder Pilzen besteht, dann wird zur Klärung der Ursache ein Abstrich genommen und im Labor aufbereitet.
Untersucht wird Flüssigkeit aus Wunden oder aber Material Deiner Haut- und Schleimhautoberflächen. Der Abstrich wird an der Stelle entnommen, an der Dein Arzt die Entzündung vermutet oder an der er eine Kontrolle durchführen möchte. Der Abstrich wird dann aufbereitet und der Erregerstamm isoliert und bestimmt. Danach kann dann eine Behandlung durchgeführt werden, weil man dann weiss, welchen Erreger man vor sich hat und gegen welche Antibiotika er möglicherweise bereits resistent ist.
1.6.2 Wie wird ein Abstrich untersucht?
In der Regel wird das zu untersuchende Material auf einen Nährboden oder eine Nährlösung gegeben und möglichst rasch ins Labor gebracht. Hier werden Bakterien- oder/und Pilzkulturen angelegt und getestet. Die Träger kommen dabei in einen Brutschrank und werden bei Körpertemperatur zur Vermehrung angeregt.
In einigen Fällen wird der Abstrich sofort auf einer dünnen Glasplatte hauchfein ausgestrichen (daher kommt das Wort "Abstrich"), eingefärbt und unter dem Mikroskop angeschaut.